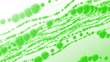

4K Colored Bubbles (seamless loop) - 4K stock video
Bubbles loopable background

PURCHASE A LICENSE
All Royalty-Free licenses include global use rights, comprehensive protection, simple pricing with volume discounts available
€475.00
EUR
DETAILS
Credit:
51³Ô¹ÏÍø #:
1310070921
License type:
Collection:
Creatas Video
Max file size:
1920 x 1080 px - 86 MB
Clip length:
00:00:12:01
Upload date:
Location:
United States
Release info:
No release required
Mastered to:
QuickTime 8-bit H.264 4K 3840x2160 29.97p
Categories:
- 4K Resolution Videos
- Abstract Videos
- Abstract Backgrounds Videos
- Animated Video Videos
- Backgrounds Videos
- Blurred Motion Videos
- Bright Videos
- Bubble Videos
- Bubble Pack Videos
- Clean
- Close-up Videos
- Cold Temperature Videos
- Color Gradient Videos
- Colored Background Videos
- Deep Videos
- Deep-Sea Diving Videos
- Defocused Videos
- Digital Animation Videos
- Distressed - Photographic Effect Videos
- Drop Videos
- Film - Moving Image Videos
- Glowing Videos
- Green Background Videos
- HD Format Videos
- High Up Videos
- Horizontal Videos
- Inspiration Videos
- Light - Natural Phenomenon Videos
- Liquid Videos
- Loopable Elements Videos
- Loopable Video Videos
- Motion Videos
- Moving Image Videos
- Nature Videos
- Night Videos
- No People Videos
- Particle Videos
- Sea Videos
- Seascape Videos
- Shiny Videos
- Slow Videos
- Slow Motion Videos
- Smooth Videos
- Softness Videos
- Surreal Videos
- USA Videos
- Water Videos
- Wave - Water Videos
- White Background Videos